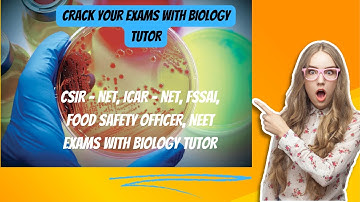
Test your microbiology knowledge with challenging MCQs! #microbiology #neet #csirnet #csir

⬇ DOWNLOAD NOW
Kalau muncul iklan pop-up, tutup lalu klik tombol kembali
Download lagu Important Probiotics MCQs | ICMR JRF | ICAR NET | DBT JRF | CSIR NET | Important MCQ of Microbiology secara gratis hanya untuk keperluan promosi. Dukung artis favorit kamu dengan membeli musik original di iTunes atau platform resmi lainnya.
 500 MCQS ON MICROBIOLOGY PART 1 | GENERAL MICROBIOLOGY MCQS |
500 MCQS ON MICROBIOLOGY PART 1 | GENERAL MICROBIOLOGY MCQS |
 MCQS ON MicroBIOLOGY #biologyclass12#csirnet #pgt #gate #tgt #uppcs #aiims #icmr #pgtprepration(3)
MCQS ON MicroBIOLOGY #biologyclass12#csirnet #pgt #gate #tgt #uppcs #aiims #icmr #pgtprepration(3)
Test your microbiology knowledge with challenging MCQs! #microbiology #neet #csirnet #csir
Test your microbiology knowledge with challenging MCQs! #microbiology #neet #csirnet #csir
 MCQ in Microbiology and Biotechnology
MCQ in Microbiology and Biotechnology
 MCQS ON AIR MICROBIOLOGY || Air Microbiology Mcq questions with answers || PART 5 || MICROBIOLOGY
MCQS ON AIR MICROBIOLOGY || Air Microbiology Mcq questions with answers || PART 5 || MICROBIOLOGY
 microbiology mcq question answers || father of microbiology
microbiology mcq question answers || father of microbiology
 ICMR JRF Mcq |Biochemistry MCQ
ICMR JRF Mcq |Biochemistry MCQ
 Medical Microbiology Important questions- ICMR/NEET/AIIMS/NET
Medical Microbiology Important questions- ICMR/NEET/AIIMS/NET